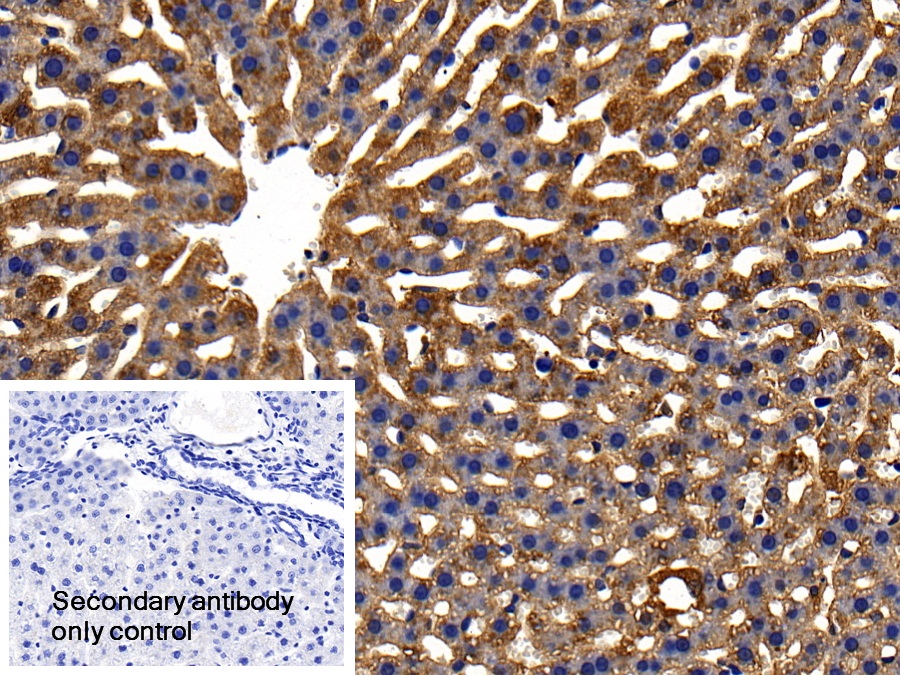

Polyclonal Antibody to Glutathione Peroxidase 1 (GPX1) 

GSHPX1; Cellular glutathione peroxidase
Overview
Properties
- Product No.PAA295Ra01
- Organism SpeciesRattus norvegicus (Rat) Same name, Different species.
- ApplicationsWB; IHC
If the antibody is used in flow cytometry, please check FCM antibodies.
Research use only - DownloadInstruction Manual
- CategoryEnzyme & KinaseMetabolic pathway
- SourcePolyclonal antibody preparation, Host Rabbit
- Ig Type IgG, Potency n/a
- PurificationAntigen-specific affinity chromatography followed by Protein A affinity chromatography
- LabelNone
- Immunogen RPA295Ra01-Recombinant Glutathione Peroxidase 1 (GPX1)
- Buffer Formulation0.01M PBS, pH7.4, containing 0.05% Proclin-300, 50% glycerol.
- TraitsLiquid, Concentration 0.3mg/mL
Sign into your account
Share a new citation as an author
Upload your experimental result
Review

Contact us
Please fill in the blank.
Specifity
The antibody is a rabbit polyclonal antibody raised against GPX1. It has been selected for its ability to recognize GPX1 in immunohistochemical staining and western blotting.
Usage
Western blotting: 0.01-2µg/mL;
Immunohistochemistry: 5-20µg/mL;
Optimal working dilutions must be determined by end user.
Storage
Store at 4°C for frequent use. Stored at -20°C in a manual defrost freezer for two year without detectable loss of activity. Avoid repeated freeze-thaw cycles.
Stability
The thermal stability is described by the loss rate. The loss rate was determined by accelerated thermal degradation test, that is, incubate the protein at 37°C for 48h, and no obvious degradation and precipitation were observed. The loss rate is less than 5% within the expiration date under appropriate storage condition.
Organism Species More: Homo sapiens (Human), Mus musculus (Mouse)Giveaways
Increment services
-
 Antibody Labeling Customized Service
Antibody Labeling Customized Service
-
 Protein A/G Purification Column
Protein A/G Purification Column
-
 Staining Solution for Cells and Tissue
Staining Solution for Cells and Tissue
-
 Positive Control for Antibody
Positive Control for Antibody
-
 Tissue/Sections Customized Service
Tissue/Sections Customized Service
-
 Phosphorylated Antibody Customized Service
Phosphorylated Antibody Customized Service
-
 Western Blot (WB) Experiment Service
Western Blot (WB) Experiment Service
-
 Immunohistochemistry (IHC) Experiment Service
Immunohistochemistry (IHC) Experiment Service
-
 Immunocytochemistry (ICC) Experiment Service
Immunocytochemistry (ICC) Experiment Service
-
 Flow Cytometry (FCM) Experiment Service
Flow Cytometry (FCM) Experiment Service
-
 Immunoprecipitation (IP) Experiment Service
Immunoprecipitation (IP) Experiment Service
-
 Immunofluorescence (IF) Experiment Service
Immunofluorescence (IF) Experiment Service
-
 Buffer
Buffer
-
 DAB Chromogen Kit
DAB Chromogen Kit
-
 SABC Kit
SABC Kit
-
 Long-arm Biotin Labeling Kit
Long-arm Biotin Labeling Kit
-
 Real Time PCR Experimental Service
Real Time PCR Experimental Service
Citations
- P2×7?Receptor in the Kidneys of Diabetic Rats Submitted to Aerobic Training or to N-Acetylcysteine SupplementationPlos:Source
- Consequences of age on ischemic wound healing in rats: altered antioxidant activity and delayed wound closurePubmed:24443098
- Determination of Gene Expression and Serum Levels of MnSOD and GPX1 in Colorectal CancerPubmed:25550558
- Genetic polymorphisms (Pro197Leu of Gpx1, +35A/C of SOD1, PubMed: 26674569
- Seasonal Variation in Glutathione Peroxidase in Seminal Plasma of Karan Fries (Tharparkar X Holstein Friesian) Bulls Under Tropical Climatic Conditionspublication:301246301
- Influence of season on seminal antioxidant enzymes in Karan Fries bulls under tropical climatic conditionsfileID:697741
- Evaluation of hepatorenal impairments in Wistar rats coexposed to low-dose lead, cadmium and manganese: insights into oxidative stress mechanismpubmed:27599793
- Reduced Dietary Selenium Impairs Vascular Function by Increasing Oxidative Stress in Sprague-Dawley Rat Aortas.pubmed:28574428
- Assessing the serum concentration levels of NT-4/5, GPX-1, TNF-α, and l-arginine as biomediators of depression severity in first depressive episode patients with and without posttraumatic stress disorder.pubmed:28958613
- Peripheral levels of superoxide dismutase and glutathione peroxidase in youths in ultra-high risk for psychosis: a pilot studypubmed:29248027
- Dyslipdemia induced by chronic low dose co-exposure to lead, cadmium and manganese in rats: the role of oxidative stresspubmed:28654832
- Selenium- Essential Antioxidant Elemen the example of autoimune thyroiditispdf:44%20PREDA%20C%207%2017.pdf
- Seasonal variation of mitochondria activity related and heat shock protein genes in spermatozoa of Karan Fries bulls in tropical climate10.1080:09291016.2017.1361584
- Investigation of GPX1 Gene Expression, Serum GPX1 and Selenium Levels on Colorectal Cancer
- Kolon Kanserinde Gpx1 Gen Anlatımı, Serum Gpx1 ve Selenyum Düzeylerinin İncelenmesi
- Influence of deficient nutrition on trace element status and antioxidant defense systemPubmed: 1781925
- Glutathione, glutathione peroxidase and some hematological parameters of HIV-seropositive subjects attending clinic in University of Calabar teaching …Pubmed: 31703562
- Rapamycin improves renal injury induced by Iodixanol in diabetic rats by deactivating the mTOR/p70S6K signaling pathwayPubmed: 32798557
- AMELIORATIVE EFFECT OF AQUEOUS EXTRACT OF HIBISCUS SABDARIFFA (ROSELLE) ON SALT-INDUCED HYPERTENSION IN WISTAR RATS
- In Vitro Cell Culture Study of Anticholesterol and Antioxidant Activities of Myrmecodia platytyrae (MyP) Extract in WRL-68 Cells
- Effects of Ganoderma lucidum polysaccharides on different pathways involved in the development of spinal cord ischemia reperfusion injury: biochemical ¡33689849
- Associations of Antioxidant Enzymes with the Concentration of Fatty Acids in the Blood of Men with Coronary Artery Atherosclerosis34945751
- Intake of Bifidobacterium lactis Probio-M8 fermented milk protects against alcoholic liver diseasePubmed:35086715
- A Famous Chinese Medicine Formula: Yinhuo Decoction Antagonizes the Damage of Corticosterone to PC12 Cells and Improves Depression by Regulating …Pubmed:35281603